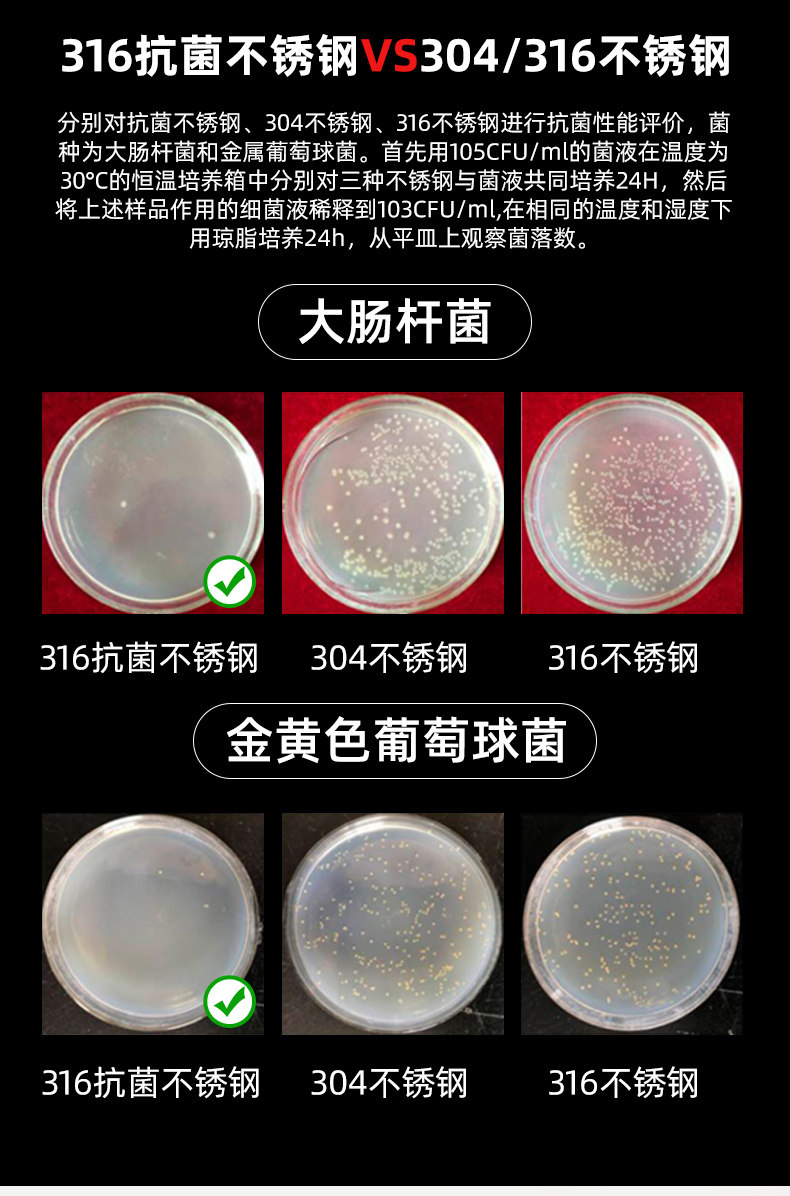

- Таобао
- Всё для кухни
- Кухонная утварь
- Разделочные доски
- 642090427819
onlycook Антибактериальная и мильда 316 из нержавеющей стали катчиальные тарелки Домохозяйственное шкаф с двойной кухонной доской кухонной доски фрукты

Цена: 1 437-2 346руб. (¥68)
Артикул: 642090427819
Вес товара: ~0.7 кг. Указан усредненный вес, который может отличаться от фактического. Не включен в цену, оплачивается при получении.
Описание товараPGRpdj48aW1nIHNyYz0iaHR0cHM6Ly9pbWcuYWxpY2RuLmNvbS9pbWdleHRyYS9pNC8xODUyMjk3NTIzL08xQ04wMVdXWFdxWjI1UmFJTTNDTVhOXyEhMTg1MjI5NzUyMy5qcGciPjwvZGl2PjxkaXY+PGltZyBzcmM9Imh0dHBzOi8vaW1nLmFsaWNkbi5jb20vaW1nZXh0cmEvaTEvMTg1MjI5NzUyMy9PMUNOMDEzNExOaEkyNVJhSU9NSnZpT18hITE4NTIyOTc1MjMuanBnIj48L2Rpdj48ZGl2PjxpbWcgc3JjPSJodHRwczovL2ltZy5hbGljZG4uY29tL2ltZ2V4dHJhL2kzLzE4NTIyOTc1MjMvTzFDTjAxU1NVdzl5MjVSYUlMMU12SUFfISExODUyMjk3NTIzLmpwZyI+PC9kaXY+PGRpdj48aW1nIHNyYz0iaHR0cHM6Ly9pbWcuYWxpY2RuLmNvbS9pbWdleHRyYS9pMy8xODUyMjk3NTIzL08xQ04wMVpwcXJBdjI1UmFJS1ZYdU1MXyEhMTg1MjI5NzUyMy5qcGciPjwvZGl2PjxkaXY+PGltZyBzcmM9Imh0dHBzOi8vaW1nLmFsaWNkbi5jb20vaW1nZXh0cmEvaTEvMTg1MjI5NzUyMy9PMUNOMDF5RHduSjgyNVJhSUVENGNHS18hITE4NTIyOTc1MjMuanBnIj48L2Rpdj48ZGl2PjxpbWcgc3JjPSJodHRwczovL2ltZy5hbGljZG4uY29tL2ltZ2V4dHJhL2kzLzE4NTIyOTc1MjMvTzFDTjAxeGRNeGVYMjVSYUlJUmR1d0JfISExODUyMjk3NTIzLmpwZyI+PC9kaXY+PGRpdj48aW1nIHNyYz0iaHR0cHM6Ly9pbWcuYWxpY2RuLmNvbS9pbWdleHRyYS9pMy8xODUyMjk3NTIzL08xQ04wMVNUbUtNRjI1UmFJTWwxMWpiXyEhMTg1MjI5NzUyMy5qcGciPjwvZGl2PjxkaXY+PGltZyBzcmM9Imh0dHBzOi8vaW1nLmFsaWNkbi5jb20vaW1nZXh0cmEvaTMvMTg1MjI5NzUyMy9PMUNOMDFPSGkwMFYyNVJhSUlBWnNTM18hITE4NTIyOTc1MjMuanBnIj48L2Rpdj48ZGl2PjxpbWcgc3JjPSJodHRwczovL2ltZy5hbGljZG4uY29tL2ltZ2V4dHJhL2kyLzE4NTIyOTc1MjMvTzFDTjAxbWhvQ0tvMjVSYUk4NXBLWWpfISExODUyMjk3NTIzLmpwZyI+PC9kaXY+PGRpdj48aW1nIHNyYz0iaHR0cHM6Ly9pbWcuYWxpY2RuLmNvbS9pbWdleHRyYS9pNC8xODUyMjk3NTIzL08xQ04wMTVCMUsyRjI1UmFJTTNIYkQxXyEhMTg1MjI5NzUyMy5qcGciPjwvZGl2PjxkaXY+PGltZyBzcmM9Imh0dHBzOi8vaW1nLmFsaWNkbi5jb20vaW1nZXh0cmEvaTQvMTg1MjI5NzUyMy9PMUNOMDFubUFoME0yNVJhSUduR3N2bF8hITE4NTIyOTc1MjMuanBnIj48L2Rpdj48ZGl2PjxpbWcgc3JjPSJodHRwczovL2ltZy5hbGljZG4uY29tL2ltZ2V4dHJhL2k0LzE4NTIyOTc1MjMvTzFDTjAxZXRoa3BqMjVSYUlMMVJNMDFfISExODUyMjk3NTIzLmpwZyI+PC9kaXY+PGRpdj48aW1nIHNyYz0iaHR0cHM6Ly9pbWcuYWxpY2RuLmNvbS9pbWdleHRyYS9pMi8xODUyMjk3NTIzL08xQ04wMVB6bVRqRTI1UmFJS1ZlWUlRXyEhMTg1MjI5NzUyMy5qcGciPjwvZGl2PjxkaXY+PGltZyBzcmM9Imh0dHBzOi8vaW1nLmFsaWNkbi5jb20vaW1nZXh0cmEvaTIvMTg1MjI5NzUyMy9PMUNOMDFwRG5raFcyNVJhSU9NTVh2OV8hITE4NTIyOTc1MjMuanBnIj48L2Rpdj48ZGl2PjxpbWcgc3JjPSJodHRwczovL2ltZy5hbGljZG4uY29tL2ltZ2V4dHJhL2kzLzE4NTIyOTc1MjMvTzFDTjAxY3AzSEhDMjVSYUlKYmxvS3lfISExODUyMjk3NTIzLmpwZyI+PC9kaXY+PGRpdj48aW1nIHNyYz0iaHR0cHM6Ly9pbWcuYWxpY2RuLmNvbS9pbWdleHRyYS9pNC8xODUyMjk3NTIzL08xQ04wMXdXd3B0aTI1UmFJODVrRUhaXyEhMTg1MjI5NzUyMy5qcGciPjwvZGl2PjxkaXY+PGltZyBzcmM9Imh0dHBzOi8vaW1nLmFsaWNkbi5jb20vaW1nZXh0cmEvaTMvMTg1MjI5NzUyMy9PMUNOMDE1YXpzUkkyNVJhSUdzQ3RDVl8hITE4NTIyOTc1MjMuanBnIj48L2Rpdj48ZGl2PjxpbWcgc3JjPSJodHRwczovL2ltZy5hbGljZG4uY29tL2ltZ2V4dHJhL2kxLzE4NTIyOTc1MjMvTzFDTjAxMVJERVlUMjVSYUlNM0V5enNfISExODUyMjk3NTIzLmpwZyI+PC9kaXY+PGRpdj48aW1nIHNyYz0iaHR0cHM6Ly9pbWcuYWxpY2RuLmNvbS9pbWdleHRyYS9pNC8xODUyMjk3NTIzL08xQ04wMTBzMzdYNTI1UmFJR25MdjFRXyEhMTg1MjI5NzUyMy5qcGciPjwvZGl2PjxkaXY+PGltZyBzcmM9Imh0dHBzOi8vaW1nLmFsaWNkbi5jb20vaW1nZXh0cmEvaTEvMTg1MjI5NzUyMy9PMUNOMDF5ZEZvRHEyNVJhSUtWZmw4a18hITE4NTIyOTc1MjMuanBnIj48L2Rpdj48ZGl2PjxpbWcgc3JjPSJodHRwczovL2ltZy5hbGljZG4uY29tL2ltZ2V4dHJhL2kzLzE4NTIyOTc1MjMvTzFDTjAxZDhEQlBIMjVSYUlNM0gzeHJfISExODUyMjk3NTIzLmpwZyI+PC9kaXY+PGRpdj48aW1nIHNyYz0iaHR0cHM6Ly9pbWcuYWxpY2RuLmNvbS9pbWdleHRyYS9pNC8xODUyMjk3NTIzL08xQ04wMVdGd1BEVzI1UmFJR3NEOW9CXyEhMTg1MjI5NzUyMy5qcGciPjwvZGl2Pg==
Продавец:onlycook旗舰店
Адрес:Чжэцзян
Рейтинг:

Всего отзывов:0
Положительных:0
Выберите вариацию / цвет
Добавить в корзину
- Информация о товаре
- Фотографии
| Цвет: | Двусторонная разделочная доска, Антибактериальная белая двусторонная разделочная доска из нержавеющей стали, Антибактериальная черная двусторонная разделочная доска из нержавеющей стали, Двойная режущая доска с ПП+шлифовальный нож, Антибактериальная белая двусторонная разделочная доска из нержавеющей стали, Антибактериальная черная двусторонная разделочная доска из нержавеющей стали |